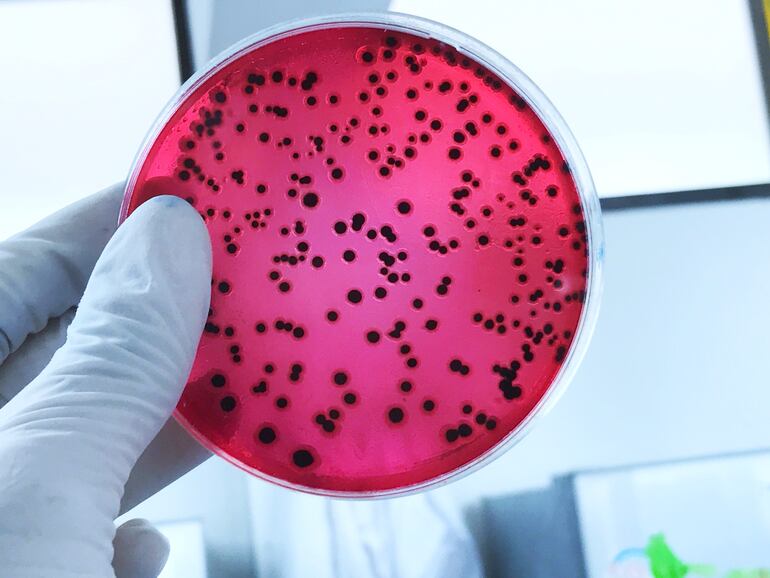

La investigación, liderada por el microbiólogo austríaco Alexander Loy del centro de Microbiología de la Universidad de Viena, demuestra que esta bacteria, a la que llamó “devorador de taurina del ratón” por su alta absorción de taurina (presente en muchas bebidas energéticas), tiene pequeñas cantidades de sulfuro de hidrógeno que son esenciales en el intestino para muchos procesos fisiológicos.
La utilidad principal de esta bacteria es la protección del intestino contra enfermedades como la salmonella, causada principalmente por la ingesta de huevos o carne en mal estado, pero también contra gérmenes hospitalarios, cada vez más extendidos.
Gérmenes hospitalarios
“En los gérmenes hospitalarios, el sulfuro de hidrógeno bloquea el sitio de unión para el oxígeno en el centro activo de las enzimas de la cadena respiratoria”, explicó Loy a la agencia austríaca APA.
No obstante, el ácido sulfúrico, un gas que provoca flatulencias de muy mal olor y es el principal culpable del mal aliento, es peligroso en grandes cantidades, pues llevan a los humanos a perder la capacidad de olerlo y se vuelve venenoso.
Se encuentra, además de en nuestro sistema digestivo en muy pequeñas cantidades, entre los gases de volcanes, en manantiales de azufre, pantanos, aguas estancadas y en el petróleo crudo.